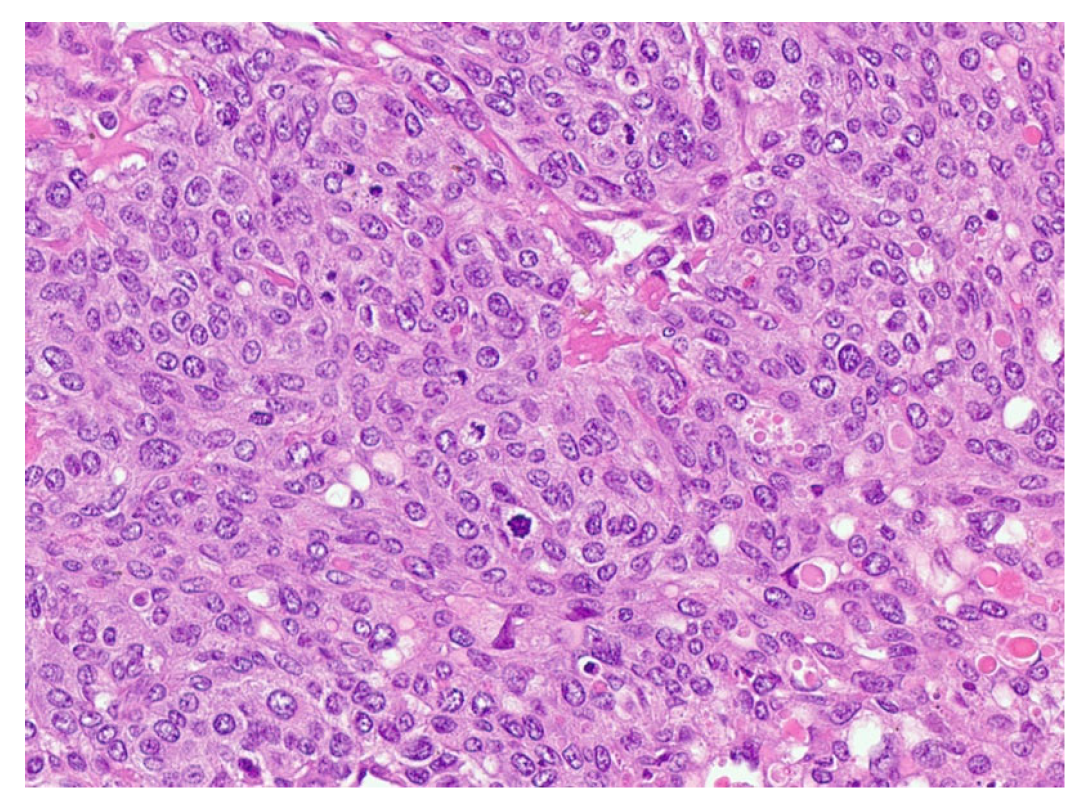
Jcm 13 03436 g004

Germ Cell Tumor of the Testis: Lethal Subtypes of a Curable Cancer
Abstract
1. Introduction
2. Case Reports
3. Discussion
4. Conclusions
Author Contributions
Funding
Institutional Review Board Statement
Informed Consent Statement
Data Availability Statement
Conflicts of Interest
Abbreviations
| AFP | Alpha fetoprotein |
| BEP | Bleomycin, etoposide, cisplatin |
| CT | Computed tomography |
| EP | Etoposide and cisplatin |
| ETT | Epithelioid trophoblastic tumor |
| GCT | Germ cell tumor |
| HCG | Beta-human chorionic gonadotropin |
| ILND | Inguinal lymph node dissection |
| LDH | Lactate dehydrogenase |
| LN | Lymph node |
| NSGCT | Nonseminomatous germ cell tumor |
| POMB | Cisplatin, vincristine, methotrexate, and bleomycin |
| RPLN | Retroperitoneal lymph node |
| RPLND | Retroperitoneal lymph node dissection |
| S-YST | Sarcomatoid yolk sac tumor |
| TIP | Paclitaxel, ifosfamide, cisplatin |
| VIP | Cisplatin, etoposide, ifosfamide |
References
- Tu, S.M.; Bilen, M.A.; Hess, K.R.; Broaddus, R.R.; Kopetz, S.; Wei, C.; Pagliaro, L.C.; Karam, J.A.; Ward, J.F.; Wood, C.G.; et al. Intratumoral heterogeneity: Role of differentiation in a potentially lethal phenotype of testicular cancer. Cancer 2016, 122, 1836–1843. [Google Scholar] [CrossRef] [PubMed]
- Funt, S.A.; Patil, S.; Feldman, D.R.; Motzer, R.J.; Bajorin, D.F.; Sheinfeld, J.; Tickoo, S.K.; Reuter, V.E.; Bosl, G.J. Impact of Teratoma on the Cumulative Incidence of Disease-Related Death in Patients with Advanced Germ Cell Tumors. J. Clin. Oncol. 2019, 37, 2329–2337. [Google Scholar] [CrossRef]
- Howitt, B.E.; Magers, M.J.; Rice, K.R.; Cole, C.D.; Ulbright, T.M. Many postchemotherapy sarcomatous tumors in patients with testicular germ cell tumors are sarcomatoid yolk sac tumors: A study of 33 cases. Am. J. Surg. Pathol. 2015, 39, 251–259. [Google Scholar] [CrossRef] [PubMed]
- Damjanov, I.; Amenta, P.S.; Zarghami, F. Transformation of an AFP-positive yolk sac carcinoma into an AFP-negative neoplasm. Evidence for in vivo cloning of the human parietal yolk sac carcinoma. Cancer 1984, 53, 1902–1907. [Google Scholar] [CrossRef] [PubMed]
- Michael, H.; Ulbright, T.M.; Brodhecker, C.A. The Pluripotential Nature of the Mesenchyme-Like Component of Yolk-Sac Tumor. Arch. Pathol. Lab. Med. 1989, 113, 1115–1119. [Google Scholar] [PubMed]
- Keser, S.H.; Kokten, S.C.; Cakir, C.; Sensu, S.; Buyukbayrak, E.E.; Karadayi, N. Epithelioid trophoblastic tumor. Taiwan J. Obstet. Gynecol. 2015, 54, 621–624. [Google Scholar] [CrossRef] [PubMed]
- Lewin, S.N.; Aghajanian, C.; Moreira, A.L.; Soslow, R.A. Extrauterine epithelioid trophoblastic tumors presenting as primary lung carcinomas: Morphologic and immunohistochemical features to resolve a diagnostic dilemma. Am. J. Surg. Pathol. 2009, 33, 1809–1814. [Google Scholar] [CrossRef] [PubMed]
- Jordan, S.; Randall, L.M.; Karamurzin, Y.; Ward, P.; Lin, F.; Brewster, W.; Monk, B.J. Differentiating squamous cell carcinoma of the cervix and epithelioid trophoblastic tumor. Int. J. Gynecol. Cancer 2011, 21, 918–922. [Google Scholar] [CrossRef] [PubMed]
- Shet, T.; Parage, M.; Maheshwari, A.; Nair, R.; Gupta, S.; Tongaonkar, H.; Chinoy, R. Epithelioid trophoblastic tumor of uterus presenting as an ovarian mass: A diagnostic and therapeutic dilemma. Indian J. Pathol. Microbiol. 2008, 51, 242–244. [Google Scholar] [CrossRef]
- Gilligan, T.; Lin, D.W.; Aggarwal, R.; Chism, D.; Cost, N.; Derweesh, I.H.; Emamekhoo, H.; Feldman, D.R.; Geynisman, D.M.; Hancock, S.L.; et al. Testicular Cancer, Version 2.2020, NCCN Clinical Practice Guidelines in Oncology. J. Natl. Compr. Cancer Netw. 2019, 17, 1529–1554. [Google Scholar] [CrossRef] [PubMed]
- Oldenburg, J.; Berney, D.; Bokemeyer, C.; Climent, M.; Daugaard, G.; Gietema, J.; De Giorgi, U.; Haugnes, H.; Huddart, R.; Leão, R.; et al. Testicular seminoma and non-seminoma: ESMO-EURACAN Clinical Practice Guideline for diagnosis, treatment and follow-up. Ann. Oncol. 2022, 33, 362–375. [Google Scholar] [CrossRef] [PubMed]
- Moore, J.A.; Slack, R.S.; Lehner, M.J.; Campbell, M.T.; Shah, A.Y.; Zhang, M.; Guo, C.C.; Ward, J.F.; Karam, J.A.; Wood, C.G.; et al. Very Late Recurrence in Germ Cell Tumor of the Testis: Lessons and Implications. Cancers 2022, 14, 1127. [Google Scholar] [CrossRef] [PubMed]
- Tu, S.M.; Zhang, M.; Wood, C.G.; Pisters, L.L. Stem Cell Theory of Cancer: Origin of Tumor Heterogeneity and Plasticity. Cancers 2021, 13, 4006. [Google Scholar] [CrossRef] [PubMed]
- Friedman, N.B.; Moore, R.A. Tumors of the Testis—A Report on 922 Cases. J. Urol. 1947, 57, 1199–1201. [Google Scholar] [CrossRef] [PubMed]
- Einhorn, L.H.; Donohue, J. Cis-diamminedichloroplatinum, vinblastine, and bleomycin combination chemotherapy in disseminated testicular cancer. Ann. Intern. Med. 1977, 87, 293–298. [Google Scholar] [CrossRef] [PubMed]
- Williams, S.D.; Birch, R.; Einhorn, L.H.; Irwin, L.; Greco, F.A.; Loehrer, P.J. Treatment of disseminated germ-cell tumors with cisplatin, bleomycin, and either vinblastine or etoposide. N. Engl. J. Med. 1987, 316, 1435–1440. [Google Scholar] [CrossRef] [PubMed]
- de Wit, R.; Stoter, G.; Sleijfer, D.; Neijt, J.; Huinink, W.T.B.; de Prijck, L.; Collette, L.; Sylvester, R. Four cycles of BEP vs four cycles of VIP in patients with intermediate-prognosis metastatic testicular non-seminoma: A randomized study of the EORTC Genitourinary Tract Cancer Cooperative Group. Br. J. Cancer 1998, 78, 828–832. [Google Scholar] [CrossRef] [PubMed]
- Nichols, C.R.; Catalano, P.J.; Crawford, E.D.; Vogelzang, N.J.; Einhorn, L.H.; Loehrer, P.J. Randomized comparison of cisplatin and etoposide and either bleomycin or ifosfamide in treatment of advanced disseminated germ cell tumors: An Eastern Cooperative Oncology Group, Southwest Oncology Group, and Cancer and Leukemia Group B Study. J. Clin. Oncol. 1998, 16, 1287–1293. [Google Scholar] [CrossRef] [PubMed]
- Fizazi, K.; Pagliaro, L.; Laplanche, A.; Fléchon, A.; Mardiak, J.; Geoffrois, L.; Kerbrat, P.; Chevreau, C.; Delva, R.; Rolland, F.; et al. Personalised chemotherapy based on tumour marker decline in poor prognosis germ-cell tumours (GETUG 13): A phase 3, multicentre, randomised trial. Lancet Oncol. 2014, 15, 1442–1450. [Google Scholar] [CrossRef]
- Tu, S.M.; Pisters, L.L. Curing Cancer: Lessons from a Prototype. Cancers 2021, 13, 660. [Google Scholar] [CrossRef] [PubMed]
- Kernek, K.M.; Ulbright, T.M.; Zhang, S.; Billings, S.D.; Cummings, O.W.; Henley, J.D.; Michael, H.; Brunelli, M.; Martignoni, G.; Foster, R.S.; et al. Identical allelic losses in mature teratoma and other histologic components of malignant mixed germ cell tumors of the testis. Am. J. Pathol. 2003, 163, 2477–2484. [Google Scholar] [CrossRef] [PubMed]
- Einhorn, L.H.; Brames, M.J.; Heinrich, M.C.; Corless, C.L.; Madani, A. Phase II study of imatinib mesylate in chemotherapy refractory germ cell tumors expressing KIT. Am. J. Clin. Oncol. 2006, 29, 12–13. [Google Scholar] [CrossRef] [PubMed]
- Necchi, A.; Anichini, A.; Raggi, D.; Giannatempo, P.; Magazzù, D.; Nicolai, N.; Colecchia, M.; Paolini, B.; Coradeschi, E.; Tassi, E.; et al. Brentuximab Vedotin in CD30-Expressing Germ Cell Tumors After Chemotherapy Failure. Clin. Genitourin. Cancer 2016, 14, 261–264.e4. [Google Scholar] [CrossRef] [PubMed]
- Tu, S.M. Origin of cancers. Clinical perspectives and implications of a stem-cell theory of cancer. Cancer Treat. Res. 2010, 154, v-239. [Google Scholar] [PubMed]
- Bilen, M.A.; Hess, K.R.; Campbell, M.T.; Wang, J.; Broaddus, R.R.; Karam, J.A.; Ward, J.F.; Wood, C.G.; Choi, S.L.; Rao, P.; et al. Intratumoral heterogeneity and chemoresistance in nonseminomatous germ cell tumor of the testis. Oncotarget 2016, 7, 86280–86289. [Google Scholar] [CrossRef]
- Tu, S.-M. The Story of Hydra: Portrait of Cancer as a Stem-Cell Disease. Cancer Etiology, Diagnosis and Treatments; Nova Medicine & Health: New York, NY, USA, 2019; 328p. [Google Scholar]
- Velasco, A.; Riquelme, E.; Schultz, M.; Wistuba, I.I.; Villarroel, L.; Pizarro, J.; Berlin, A.; Ittmann, M.; Koh, M.S.; Leach, F.S. Mismatch repair gene expression and genetic instability in testicular germ cell tumor. Cancer Biol. Ther. 2004, 3, 977–982. [Google Scholar] [CrossRef] [PubMed]
- McIntyre, A.; Summersgill, B.; Grygalewicz, B.; Gillis, A.J.; Stoop, J.; van Gurp, R.J.; Dennis, N.; Fisher, C.; Huddart, R.; Cooper, C.; et al. Amplification and overexpression of the KIT gene is associated with progression in the seminoma subtype of testicular germ cell tumors of adolescents and adults. Cancer Res. 2005, 65, 8085–8089. [Google Scholar] [CrossRef] [PubMed]
- Fankhauser, C.D.; Curioni-Fontecedro, A.; Allmann, V.; Beyer, J.; Tischler, V.; Sulser, T.; Moch, H.; Bode, P.K. Frequent PD-L1 expression in testicular germ cell tumors. Br. J. Cancer 2015, 113, 411–413. [Google Scholar] [CrossRef] [PubMed]
- Cierna, Z.; Mego, M.; Miskovska, V.; Machalekova, K.; Chovanec, M.; Svetlovska, D.; Hainova, K.; Rejlekova, K.; Macak, D.; Spanik, S.; et al. Prognostic value of programmed-death-1 receptor (PD-1) and its ligand 1 (PD-L1) in testicular germ cell tumors. Ann. Oncol. 2016, 27, 300–305. [Google Scholar] [CrossRef] [PubMed]
- Adra, N.; Einhorn, L.H.; Althouse, S.K.; Ammakkanavar, N.R.; Musapatika, D.; Albany, C.; Vaughn, D.; Hanna, N.H. Phase II trial of pembrolizumab in patients with platinum refractory germ-cell tumors: A Hoosier Cancer Research Network Study GU14-206. Ann. Oncol. 2018, 29, 209–214. [Google Scholar] [CrossRef] [PubMed]
- Zynger, D.L.; Dimov, N.D.; Luan, C.; Teh, B.T.; Yang, X.J. Glypican 3: A novel marker in testicular germ cell tumors. Am. J. Surg. Pathol. 2006, 30, 1570–1575. [Google Scholar] [CrossRef]

| Patient NSGCT Type | Status | Pathology of Primary | Stage at Time of Diagnosis | S-YSTemic Chemo | Date: Pathology after Chemo |
|---|---|---|---|---|---|
| 1 ETT | Cured | 100% S (elevated AFP) | IIX | BEP x1, VIP x3, paclitaxel (docetaxel), doxorubicin, gemcitabine, | 6/2012: 90% T, 10% ETT + adenocarcinoma |
| 2 S-YST | Cured | 5% E, 90% S, 5% Y | IIIC | BEP x4 | 5/2018, 4/2019, 4/2020: 99% S-YST + 1% T |
| 3 ETT | Cured | 80% ETT, 20% T | IIC | BEP x3 | 1/2018: T w/minute ETT |
| 4 S-YST | Died | NA Y in met | IIIC | BEP x4 | 9/2016: T 1/2021: S-YST |
| 5 ETT | Died | 100% E | IIIA | BEP x1, EP x3, TIP x4, POMB x2, ATP x4, TIP x1/HDC + SCT | 7/2019: Embryonal 11/2019: ETT 1/2020: Choriocarcinoma |
| 6. ETT | Died | 99% E, 1% T | IIIA | BEP x3, TIP x3, ATP | 9/2018: E, C 7/2019, 8/2019: 60% ETT + squamous cell carcinoma |
| 7 S-YST | Died | NA i(12p)+ in met | IIC | BEP x2, XELOX, ATP x2 | 8/2019: S-YST (Unresectable) |
Disclaimer/Publisher’s Note: The statements, opinions and data contained in all publications are solely those of the individual author(s) and contributor(s) and not of MDPI and/or the editor(s). MDPI and/or the editor(s) disclaim responsibility for any injury to people or property resulting from any ideas, methods, instructions or products referred to in the content. |
© 2024 by the authors. Licensee MDPI, Basel, Switzerland. This article is an open access article distributed under the terms and conditions of the Creative Commons Attribution (CC BY) license (https://creativecommons.org/licenses/by/4.0/).
Share and Cite
Jackson, J.C.; Sanchez, D.; Johns, A.C.; Campbell, M.T.; Aydin, A.M.; Gokden, N.; Maraboyina, S.; Muesse, J.L.; Ward, J.F.; Pisters, L.L.; et al. Germ Cell Tumor of the Testis: Lethal Subtypes of a Curable Cancer. J. Clin. Med. 2024, 13, 3436. https://doi.org/10.3390/jcm13123436
Jackson JC, Sanchez D, Johns AC, Campbell MT, Aydin AM, Gokden N, Maraboyina S, Muesse JL, Ward JF, Pisters LL, et al. Germ Cell Tumor of the Testis: Lethal Subtypes of a Curable Cancer. Journal of Clinical Medicine. 2024; 13(12):3436. https://doi.org/10.3390/jcm13123436
Chicago/Turabian StyleJackson, Jamaal C., Darren Sanchez, Andrew C. Johns, Matthew T. Campbell, Ahmet M. Aydin, Neriman Gokden, Sanjay Maraboyina, Jason L. Muesse, John F. Ward, Louis L. Pisters, and et al. 2024. "Germ Cell Tumor of the Testis: Lethal Subtypes of a Curable Cancer" Journal of Clinical Medicine 13, no. 12: 3436. https://doi.org/10.3390/jcm13123436
APA StyleJackson, J. C., Sanchez, D., Johns, A. C., Campbell, M. T., Aydin, A. M., Gokden, N., Maraboyina, S., Muesse, J. L., Ward, J. F., Pisters, L. L., Zacharias, N. M., Guo, C. C., & Tu, S.-M. (2024). Germ Cell Tumor of the Testis: Lethal Subtypes of a Curable Cancer. Journal of Clinical Medicine, 13(12), 3436. https://doi.org/10.3390/jcm13123436







